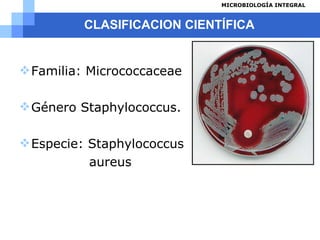
CLASIFICACION CIENTÍFICA Familia:  Micrococcaceae Género Staphylococcus. Especie: Staphylococcus aureus

El documento describe a Staphylococcus aureus, una bacteria común que se encuentra en la piel y mucosas de humanos. S. aureus puede causar una variedad de infecciones, desde leves como forúnculos hasta graves como endocarditis bacteriana. Produce toxinas que causan enfermedades mediante daño invasivo a través de estructuras de pared celular y enzimas, o toxicidad a través de potentes toxinas. La prevención incluye el lavado de manos, tratamiento de heridas y evitar la contaminación cruzada de alimentos.